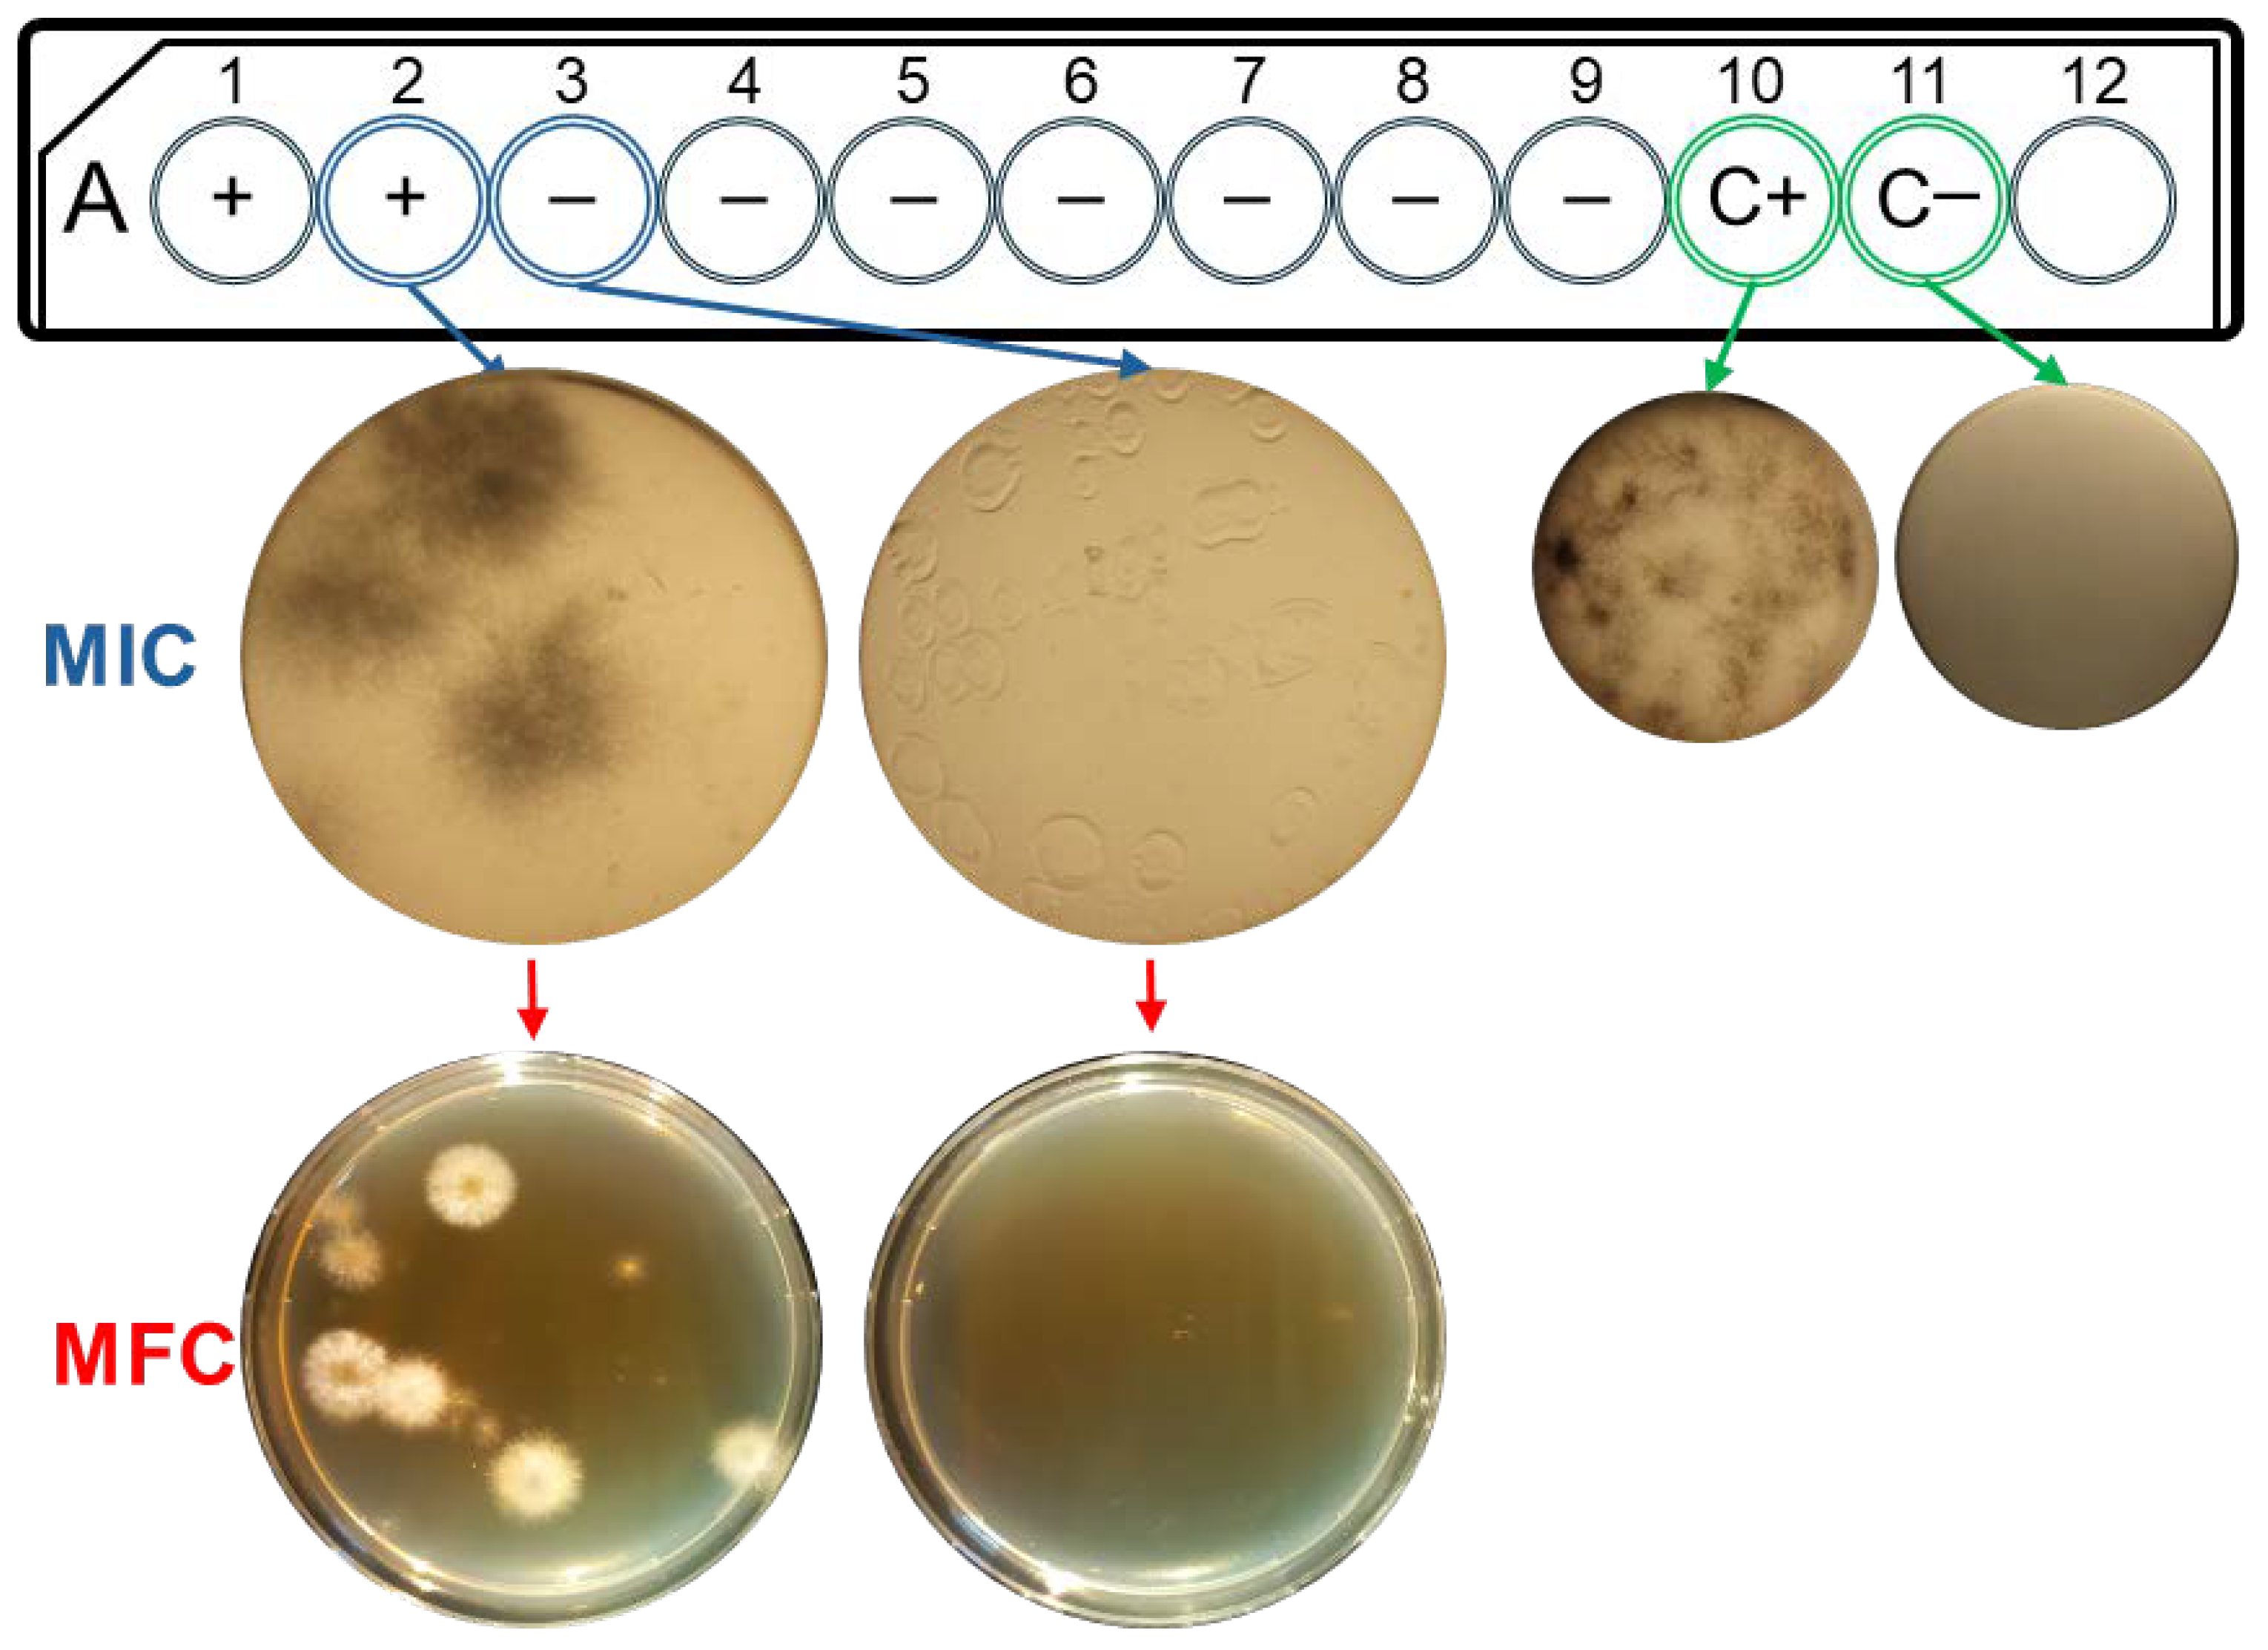
Jof 10 00675 g001

Antifungal Activity of Tea Tree (Melaleuca alternifolia Cheel) Essential Oils against the Main Onychomycosis-Causing Dermatophytes
Abstract
1. Introduction
2. Materials and Methods
2.1. Origin and Composition of Essential Oils
2.2. Microbial Strains and Inoculum Preparation
2.3. Antifungal Susceptibility Testing
3. Results
Antifungal Susceptibility Results
4. Discussion
Author Contributions
Funding
Institutional Review Board Statement
Informed Consent Statement
Data Availability Statement
Acknowledgments
Conflicts of Interest
References
- Lipner, S.R.; Scher, R.K. Onychomycosis: Clinical overview and diagnosis. J. Am. Acad. Dermatol. 2019, 80, 835–851. [Google Scholar] [CrossRef] [PubMed]
- Lee, D.K.; Lipner, S.R. Optimal diagnosis and management of common nail disorders. Ann. Med. 2022, 54, 694–712. [Google Scholar] [CrossRef] [PubMed]
- Becker, B.A.; Childress, M.A. Common Foot Problems: Over-the-Counter Treatments and Home Care. Am. Fam. Physician 2018, 98, 298–303. [Google Scholar]
- Findley, K.; Oh, J.; Yang, J.; Conlan, S.; Deming, C.; Meyer, J.A.; Schoenfeld, A.; Nomicos, E.; Park, M.; NIH Intramural Sequencing Center Comparative Sequencing Program; et al. H. Topographic diversity of fungal and bacterial communities in human skin. Nature 2013, 498, 367–370. [Google Scholar] [CrossRef]
- Bhatia, V.K.; Sharma, P.C. Epidemiological studies on dermatophytosis in human patients in Himachal Pradesh. Springerplus 2014, 3, 134. [Google Scholar] [CrossRef]
- Teixeira de Aguilar Péres, N.; Albuquerque Maranhão, F.C.; Rossi, A.; Martinez-Rossi, N.M. Dermatófitos: Interação patógeno-hospedeiro e resistência a antifúngicos. An. Bras. Dermatol. 2010, 85, 657–667. [Google Scholar] [CrossRef]
- Hube, B.; Hay, R.; Brasch, J.; Veraldi, S.; Schaller, M. Dermatomycoses and inflammation: The adaptive balance between growth, damage, and survival. J. Mycol. Med. 2015, 25, 44–58. [Google Scholar] [CrossRef]
- Joyce, A.; Gupta, A.K.; Koenig, L.; Wolcott, R.; Carviel, J. Fungal diversity and onychomycosis. J. Am. Podiatr. Med. Assoc. 2019, 109, 57–63. [Google Scholar] [CrossRef]
- Macura, A.B.; Krzyściak, P.; Skóra, M.; Gniadek, A. Case report: Onychomycosis due to Trichophyton schoenleinii. Mycoses 2012, 55, e18–e19. [Google Scholar] [CrossRef]
- Brillowska-Dąbrowska, A.; Saunte, D.M.; Arendrup, M.C. Five-Hour Diagnosis of Dermatophyte Nail Infections with Specific Detection of Trichophyton rubrum. J. Clin. Microbiol. 2007, 45, 1200–1204. [Google Scholar] [CrossRef]
- Bunyaratavej, S.; Bunyaratavej, S.; Muanprasart, C.; Matthapan, L.; Varothai, S.; Tangjaturonrusamee, C.; Pattanaprichakul, P. Endonyx onychomycosis caused by Trichophyton tonsurans. Indian J. Dermatol. Venereol. Leprol. 2015, 81, 390–392. [Google Scholar] [CrossRef] [PubMed]
- Sato, T.; Kitahara, H.; Honda, H.; Katsukawa, F.; Hiruma, M.; Yaguchi, T. Onychomycosis of the Middle Finger of a Japanese Judo Athlete due to Trichophyton tonsurans. Med. Mycol. J. 2019, 60, 1–4. [Google Scholar] [CrossRef] [PubMed]
- Gao, Y.; Zhan, P.; Hagen, F.; Menken, S.B.J.; Sun, J.; Rezaei-Matehkolaei, A.; de Hoog, S. Molecular epidemiology and in vitro antifungal susceptibility of Trichophyton schoenleinii, agent of tinea capitis favosa. Mycoses 2019, 62, 466–474. [Google Scholar] [CrossRef] [PubMed]
- Hoy, N.Y.; Leung, A.K.C.; Metelitsa, A.I.; Adams, S. New concepts in median nail dystrophy, onychomycosis, and hand, foot, and mouth disease nail pathology. ISRN Dermatol. 2012, 64, 680163. [Google Scholar] [CrossRef]
- Gupta, A.K.; Gupta, G.; Jain, H.C.; Lynde, C.W.; Foley, K.A.; Daigle, D.; Cooper, E.A.; Summerbell, R.C. The prevalence of unsuspected onychomycosis and its causative organisms in a multicentre Canadian sample of 30 000 patients visiting physicians’ offices. J. Eur. Acad. Dermatol. Venereol. 2016, 30, 1567–1572. [Google Scholar] [CrossRef]
- Chacon, A.; Franca, K.; Fernandez, A.; Nouri, K. Psychosocial impact of onychomycosis: A review. Int. J. Dermatol. 2013, 52, 1300–1307. [Google Scholar] [CrossRef]
- Leung, A.K.C.; Lam, J.M.; Leong, K.F.; Hon, K.L.; Barankin, B.; Leung, A.A.M.; Wong, A.H.C. Onychomycosis: An updated review. Recent. Pat. Inflamm. Allergy Drug Discov. 2020, 14, 32–45. [Google Scholar] [CrossRef]
- Villar Rodríguez, J.; Pérez Pico, A.M.; Mingorance Álvarez, E.; Mayordomo Acevedo, R. Meta-analysis of the antifungal activities of three essential oils as alternative therapies in dermatophytosis infections. J. Appl. Microbiol. 2022, 133, 241–253. [Google Scholar] [CrossRef]
- Hammer, K.A.; Carson, C.F.; Riley, T.V. Antifungal activity of the components of Melaleuca alternifolia (tea tree) oil. J. Appl. Microbiol. 2003, 95, 853–860. [Google Scholar] [CrossRef]
- Carson, C.F.; Hammer, K.A.; Riley, T.V. Melaleuca alternifolia (tea tree) oil: A review of antimicrobial and other medicinal properties. Clin. Microbiol. Rev. 2006, 19, 50–62. [Google Scholar] [CrossRef]
- Roana, J.; Mandras, N.; Scalas, D.; Campagna, P. Antifungal Activity of Melaleuca alternifolia Essential Oil (TTO) and Its Synergy with Itraconazole or Ketoconazole against Trichophyton rubrum. Molecules 2021, 26, 461. [Google Scholar] [CrossRef] [PubMed]
- ISO 4730:2017/Amd 1:2018; Essential Oil of Melaleuca, Terpinen-4-ol Type (Tea Tree Oil) AMENDMENT 1: Enantiomeric Distribution. ISO-International Organization for Standardization: Geneva, Switzerland, 2018. Available online: https://www.iso.org/standard/74547.html (accessed on 17 September 2024).
- Vázquez, A.; Tabanca, N.; Kendra, P.E. HPTLC Analysis and Chemical Composition of Selected Melaleuca Essential Oils. Molecules 2023, 28, 3925. [Google Scholar] [CrossRef]
- D’agostino, M.; Tesse, N.; Frippiat, J.P.; Machouart, M.; Debourgogne, A. Essential Oils and Their Natural Active Compounds Presenting Antifungal Properties. Molecules 2019, 24, 3713. [Google Scholar] [CrossRef]
- Yang, S.-A.; Jeon, S.-K.; Lee, E.-J.; Im, N.-K.; Jung, J.-Y.; Lee, I.-S. Bioactivity and Chemical Composition of the Essential oil of Tea Tree (Melaleuca alternifolia). J. Life Sci. 2008, 18, 1644–1650. [Google Scholar] [CrossRef]
- Winkelman, W.J. Aromatherapy, botanicals, and essential oils in acne. Clin. Dermatol. 2018, 36, 299–305. [Google Scholar] [CrossRef]
- Yu, D.; Wang, J.; Shao, X.; Xu, F.; Wang, H. Antifungal modes of action of tea tree oil and its two characteristic components against Botrytis cinerea. J. Appl. Microbiol. 2015, 119, 1253–1262. [Google Scholar] [CrossRef]
- ISO 4730:2017; Essential Oil of Melaleuca, Terpinen-4-Ol Type (Tea Tree Oil). International Organization for Standardization: Geneva, Switzerland, 2017. Available online: https://www.iso.org/standard/69082.html (accessed on 17 September 2024).
- Abd Rashed, A.; Rathi, D.-N.G.; Ahmad Nasir, N.A.H.; Abd Rahman, A.Z. Antifungal Properties of Essential Oils and Their Compounds for Application in Skin Fungal Infections: Conventional and Nonconventional Approaches. Molecules 2021, 26, 1093. [Google Scholar] [CrossRef]
- Da Cruz Cabral, L.; Pinto Fernadez, V.; Patriarca, A. Application of plant derived compounds to control fungal spoilage and mycotoxin production in foods. Int. J. Food Microbiol. 2013, 166, 1–14. [Google Scholar] [CrossRef] [PubMed]
- Mahmoudvand, H.; Sepahvand, A.; Jahanbakhsh, S.; Ezatpour, B.; Ayatollahi Mousavi, S.A. Evaluation of antifungal activities of the essential oil and various extracts of Nigella sativa and its main component, thymoquinone against pathogenic dermatophyte strains. J. Mycol. Med. 2014, 24, e155–e161. [Google Scholar] [CrossRef]
- Mertas, A.; Garbusińska, A.; Szliszka, E.; Jureczko, A.; Kowalska, M.; Król, W. The Influence of Tea Tree Oil (Melaleuca alternifolia) on Fluconazole Activity against Fluconazole-Resistant Candida albicans Strains. Biomed. Res. Int. 2015, 2015, 590470. [Google Scholar] [CrossRef]
- Pérez Pico, A.M.; Mingorance Álvarez, E.; Pérez Luque, C.; Mayordomo Acevedo, R. Adquisición de competencias para el diagnóstico de onicomicosis mediante entrenamiento práctico podológico preclínico y clínico. Educ. Med. Super. 2019, 33, e1962. [Google Scholar]
- Baran, R.; Haneke, E.; Hay, R.J.; Piraccini, B.M.; Tosti, A. Onychomycosis. In The Current Approach to Diagnosis and Therapy, 2nd ed.; Baran, R., Haneke, E., Hay, R.J., Piraccini, B.M., Tosti, A., Eds.; CRC Press: London, UK, 1999; ISBN 9781032477862. [Google Scholar]
- Koneman, E.W.; Roberts, G.D. Micología Práctica de Laboratorio, 3rd ed.; Editorial Panamericana: Buenos Aires, Argentina, 1987; ISBN 978-950-06-1229-6. [Google Scholar]
- Arendrup, M.C.; Kahlmeter, G.; Guinea, J.; Meletiadis, J. How to: Perform antifungal susceptibility testing of microconidia-forming dermatophytes following the new reference EUCAST method E.Def 11.0, exemplified by Trichophyton. Clin. Microbiol. Infect. 2021, 27, 55–60. [Google Scholar] [CrossRef] [PubMed]
- Trifan, A.; Bostănaru, A.-C.; Luca, S.V.; Temml, V.; Akram, M.; Herdlinger, S.; Kulinowski, Ł.; Skalicka-Woźniak, K.; Granica, S.; Czerwińska, M.E.; et al. Honokiol and magnolol: Insights into their antidermatophytic effects. Plants 2021, 10, 2522. [Google Scholar] [CrossRef]
- Trifan, A.; Luca, S.V.; Bostănaru, A.-C.; Brebu, M.; Jităreanu, A.; Romeo-Teodor, C.; Skalicka-Woźniak, K.; Granica, S.; Czerwińska, M.E.; Kruk, A.; et al. Apiaceae essential oils: Boosters of terbinafine activity against dermatophytes and potent anti-inflammatory effectors. Plants 2021, 10, 2378. [Google Scholar] [CrossRef]
- Hammer, K.A.; Carson, C.F.; Riley, T.V. In vitro activity of Melaleuca alternifolia (tea tree) oil against dermatophytes and other filamentous fungi. J. Antimicrob. Chemoth. 2002, 50, 195–199. [Google Scholar] [CrossRef]
- Gupta, A.K.; Mays, R.R.; Versteeg, S.G.; Shear, N.H.; Piguet, V. Update on current approaches to diagnosis and treatment of onychomycosis. Expert. Rev. Anti Infect. Ther. 2018, 16, 929–938. [Google Scholar] [CrossRef]
- Gupta, A.K.; Sibbald, R.G.; Andriessen, A.; Belley, R.; Boroditsky, A.; Botros, M.; Chelin, R.; Gulliver, W.; Keast, D.; Raman, M. Toenail onychomycosis—A Canadian approach with a new transungual treatment: Development of a clinical pathway. J. Cutan. Med. Surg. 2015, 19, 440–449. [Google Scholar] [CrossRef]
- Oil, T. The European Cosmetics Association Colipa. Recommendations on Tea-Tree Oil. 2002. Available online: https://colipa.eu/european-cosmetics-association/ (accessed on 17 September 2024).
- Flores, F.C.; Beck, R.C.R.; da Silva, C.B. Essential oils for treatment for onychomycosis: A mini-review. Mycopathology 2015, 181, 9–15. [Google Scholar] [CrossRef] [PubMed]
- Pontón, J. La pared celular de los hongos y el mecanismo de acción de la anidulafungina. Rev. Iberoam. Micol. 2008, 25, 78–82. [Google Scholar] [CrossRef]
- Martinez-Rossi, N.M.; Peres, N.T.A.; Rossi, A. Antifungal resistance mechanisms in dermatophytes. Mycopathology 2008, 166, 369–383. [Google Scholar] [CrossRef]
- Iglesias Sánchez, M.; Pérez Pico, A.M.; Muñoz del Rey, J.; Ledesma Alcázar, M.; Mayordomo Acevedo, R. Métodos moleculares: Reacción en cadena de la polimerasa (PCR), frente a medios de cultivo convencionales. Análisis comparativo en la detección de hongos dermatofitos. Rev. Esp. Pod. 2011, 22, 146–149. [Google Scholar]
- Chatterjee, M.; Datta, D. Trichophyton: Changing Nomenclature and Practical Implications. Indian J. Dermatol. 2023, 68, 503–507. [Google Scholar] [CrossRef] [PubMed]
| Component | Naissence® | Marnys® | Esencias Lozano® |
|---|---|---|---|
| Terpinen-4-ol | 41.90% | 44.84% | 40.76% |
| Alpha terpineol | n.d. | 2.78% | 4.41% |
| Eucalyptol | 2.30% | 4.23% | 1.74% |
| Para Mentha-1,4-Diene | 22.20% | n.d. | n.d. |
| Alpha Terpinene | 10.90% | 10.92% | 10.10% |
| Gammaterpinene | n.d. | 22.31% | 20.23% |
| Alpha Terpinolene | 3.0% | n.d. | n.d. |
| Terpinolene | n.d. | 2.77% | 3.17% |
| Alpha Pinene | 3.90% | 3.94% | 2.17% |
| Beta Pinene | n.d. | 0.38% | n.d. |
| Para Cymene | 3.60% | 2.72% | 2.44% |
| Limonene | 2.80% | 2.67% | n.d. |
| Sabinene | 0.20% | 0.24% | n.d. |
| Aromadendrene | 0.70% | 2.13% | 0.45% |
| Aromadendrene Isomer | n.d. | 0.09% | n.d. |
| Allo Aromandendrene | n.d. | 0.31% | n.d. |
| Cadinene | n.d. | 0.01% | n.d. |
| Delta Cadineno | n.d. | n.d. | 1.62% |
| Globulol | n.d. | 0.24% | n.d. |
| Viridiflorol | n.d. | 0.06% | n.d. |
| Para Ment-3-Ene | n.d. | 0.08% | n.d. |
| Beta Myrcene | n.d. | 0.07% | n.d. |
| Alpha Phellandrene | n.d. | 0.15% | n.d. |
| Linalool | n.d. | 0.03% | n.d. |
| Beta Caryophyllene | n.d. | 0.17% | 0.27% |
| Cis-P-Menth-2-En-1-Ol | n.d. | 0.07% | n.d. |
| Cadina-3,5-Diene | n.d. | 0.23% | n.d. |
| Zonarene | n.d. | 0.04% | n.d. |
| Alpha Humulene + Cis-Piperitol | n.d. | 0.05% | n.d. |
| Neral | n.d. | 0.05% | n.d. |
| Ledene | n.d. | 0.78% | n.d. |
| Alpha Muurolene + B-Selinene | n.d. | 0.09% | n.d. |
| Geranial + A-Selinene | n.d. | 0.14% | n.d. |
| Spathulenol | n.d. | 0.00% | n.d. |
| Strain | Units | Esencias Lozano® | Naissance® | Marnys® | |||
|---|---|---|---|---|---|---|---|
| MIC | MFC | MIC | MFC | MIC | MFC | ||
| T. schoenleinii | % (v/v) | 0.4 3.582 | 0.4 3.582 | 0.4 3.582 | 0.4 3.582 | 0.4 3.582 | 0.4 3.582 |
| mg/L | |||||||
| T. tonsurans | % (v/v) | 0.09 805.95 | 0.09 805.95 | 0.09 805.95 | 0.09 805.95 | 0.09 805.95 | 0.09 805.95 |
| mg/L | |||||||
| T. rubrum | % (v/v) | 0.03 268.65 | 0.03 268.65 | 0.03 268.65 | 0.03 268.65 | 0.03 268.65 | 0.03 268.65 |
| mg/L | |||||||
Disclaimer/Publisher’s Note: The statements, opinions and data contained in all publications are solely those of the individual author(s) and contributor(s) and not of MDPI and/or the editor(s). MDPI and/or the editor(s) disclaim responsibility for any injury to people or property resulting from any ideas, methods, instructions or products referred to in the content. |
© 2024 by the authors. Licensee MDPI, Basel, Switzerland. This article is an open access article distributed under the terms and conditions of the Creative Commons Attribution (CC BY) license (https://creativecommons.org/licenses/by/4.0/).
Share and Cite
Mingorance Álvarez, E.; Villar Rodríguez, J.; López Ripado, O.; Mayordomo, R. Antifungal Activity of Tea Tree (Melaleuca alternifolia Cheel) Essential Oils against the Main Onychomycosis-Causing Dermatophytes. J. Fungi 2024, 10, 675. https://doi.org/10.3390/jof10100675
Mingorance Álvarez E, Villar Rodríguez J, López Ripado O, Mayordomo R. Antifungal Activity of Tea Tree (Melaleuca alternifolia Cheel) Essential Oils against the Main Onychomycosis-Causing Dermatophytes. Journal of Fungi. 2024; 10(10):675. https://doi.org/10.3390/jof10100675
Chicago/Turabian StyleMingorance Álvarez, Esther, Julia Villar Rodríguez, Olga López Ripado, and Raquel Mayordomo. 2024. "Antifungal Activity of Tea Tree (Melaleuca alternifolia Cheel) Essential Oils against the Main Onychomycosis-Causing Dermatophytes" Journal of Fungi 10, no. 10: 675. https://doi.org/10.3390/jof10100675
APA StyleMingorance Álvarez, E., Villar Rodríguez, J., López Ripado, O., & Mayordomo, R. (2024). Antifungal Activity of Tea Tree (Melaleuca alternifolia Cheel) Essential Oils against the Main Onychomycosis-Causing Dermatophytes. Journal of Fungi, 10(10), 675. https://doi.org/10.3390/jof10100675

